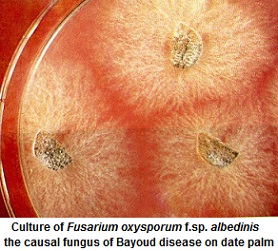
Fusarium oxysporum f.sp. albedinis. Culture

The plant peroxidases is frequently associated with plant resistance against pathogens. Peroxidases (POX) catalyse the oxidation of substrates like phenol and its derivates, by hydrogen peroxide. They are responsible for the radical dehydrogenation of sinapyl alcohol and coniferyl alcohol during the lignin synthesis.
Master commun: Microbiologie appliquée-Gestion et valorisation des phytoressources, Module 'Phytopathologie et méthodes de lutte'
Plant peroxidase actions

Horseradish peroxidase is an important heme-containing enzyme that has been studied for more than a century.
Peroxidase reactions
Most reactions catalysed by plant peroxidase can be expressed by the following equation:
H2O2 + AH2 ------ 2 H2O + 2 AH. , in which AH2 and AH. represent a reducing substrate and its radical product, respectively.
Reducing
substrates include aromatic phenols, phenolic acids, indoles, amines and sulfonates.
Date palm peroxidase. Test of activity using guaiacol as substrate (students in a training work)
The conversion of hydrogen peroxide to water is not the primary function of class III plant peroxidases. Other enzymes, including ascorbate peroxidase (class I), are used by plants to regulate levels of intracellular hydrogen peroxide. Peroxidase contains two different types of metal centre, iron(III) protoporphyrin IX (usually referred to as the heme group') and two calcium atoms. Both are essential for the structural and functional integrity of the enzyme. Plant peroxidase contains several carbohydrate (sugars) residues.

The conversion of hydrogen peroxide to water is not the primary function of class III plant peroxidases. Other enzymes, including ascorbate peroxidase (class I), are used by plants to regulate levels of intracellular hydrogen peroxide. Peroxidase contains two different types of metal centre, iron(III) protoporphyrin IX (usually referred to as the heme group') and two calcium atoms. Both are essential for the structural and functional integrity of the enzyme. Plant peroxidase contains several carbohydrate (sugars) residues.
Peroxidases are frequently associated with plant defense against pathogens. Peroxidases catalyse the oxidation of substrates like phenol and its derivates, by hydrogen peroxide. They are responsible
for the radical dehydrogenation of sinapyl alcohol and coniferyl
alcohol during the lignin synthesis.

Peroxidases participate in the synthesis of flavons, stilbens and other phenolic secondary metabolites. They are represented by many of the isoenzymes. Peroxidase polymorphism could be also used as a biochemical marker related to the different levels of field resistance. Peroxidase participate in processes which occur in the extracellular matrix. Their association with the cell wall was confirmed.
Peroxidases remove the toxic hydrogen peroxide from tissues, participate in synthesis of phenolic compounds and in the building of intermolecular bonds during the organisation of the cell wall at the sites of infection by pathogens. The production of phenolic compounds include synthesis of quinons, tanins, melanins and also the polymerization of lignin
and suberin composing monomers.
Tanins and melanins are dihydroxyphenol and chinon oligomers, these are toxic for pathogens. Lignin and suberin are involved to structural defenses. Peroxidase also participates in the synthesis of ethylene
the concentration of which increases frequently in pathogenesis process.
Generally peroxidases enhance their activity after a pathogen attack, because they participate in defensive lignification and synthesis of phenolic compounds effective against pathogens.
Date palm. Resistance of date palm to Bayoud disease (Biochemical and molecular aspects)
الجانب البيوكيميائي و الجزيئي لمقاومة مرض البيوض عند نخيل التمر
External symptoms of Bayoud
Internal symptoms of Bayoud

FOA culture
The causal agent of Bayoud disease. Fusarium oxysporum f.sp.albedinis


During the last years, studies on Bayoud disease resistance leaded to the discovery of biomlecules such as enzymes, which could play a role in the resistance mechanism of date palm against Fusarium oxysporum f.sp. albedinis, the causal agent of the fusariosis. Thus, peroxidase enzymes were found to be more represented in resistant date palm cultivars when compared with susceptible varieties.
عرفت دراسات الجانب البيوكيميائي و الجزيئي لمقاومة مرض البيوض عند نخيل التمر تطورا ملموسا في السنين الأخيرة. هكذا تم التوصل إلى استخلاص جزيئات أنزيمية قد تلعب دورا مهما في مقاومة مرض البيوض لكونها توجد بتركيزات مرتفعة في الأصناف المقاومة. بعض هذه الجزيئات لها طابع تأكسدي-اختزالي، مثل أنزيم البيروكسيداز (Peroxidase).أظهر أنزيم البيروكسيداز نشاطا مرتفعا في أوراق أصناف نخيل التمر التي تمتاز بمقاومة مرتفعة لمرض البيوض. يقد نشر هذا البحث لأول مرة سنة 1989 بمجلة New Phytologist لصاحبه م. بعزيز.



أكدت الأبحاث التي أجريت على فسائل النوى ترابط ارتفاع نشاط أنزيم البيروكسيداز في الورق و مقاومة الفسائل للفطر المسبب للبيوض. بعد حقنها بفطر فوزاريوم المسبب للبيوض، أبدت الفسائل المتميزة بمخزون مرتفع من الأنزيم مقاومة عالية للمرض (ظهور قليل جدا للأعراض الخارجية للبيوض).
Studies carried out on date palm seedlings confirmed the relationship between plant resistance against Bayoud disease and high contents of peroxidase activities.

USEFUL LINKS
- Plant resistance against pathogens. Contents
- Fungal diseases
- Passive defenses
- Active defenses
- Chitinase example
- Engineerd plants for resistance
- QCM Résistances des plantes aux pathogènes
Exams:
- Master exam June 10, 2016 (chitinase)
- Contrôle
S6 sur transformation génétique du tabac et de la pomme de terre par le gène de la chitinase de Trichoderma harzianum
Biotech-ecolo. net. SUPPORTS
CHAINE YOUTUBE
Chaine Youtube (abonnement). Plusieurs vidéos multilingues (+ s/titres) aux sujets des Biotechnologies et Biochimie